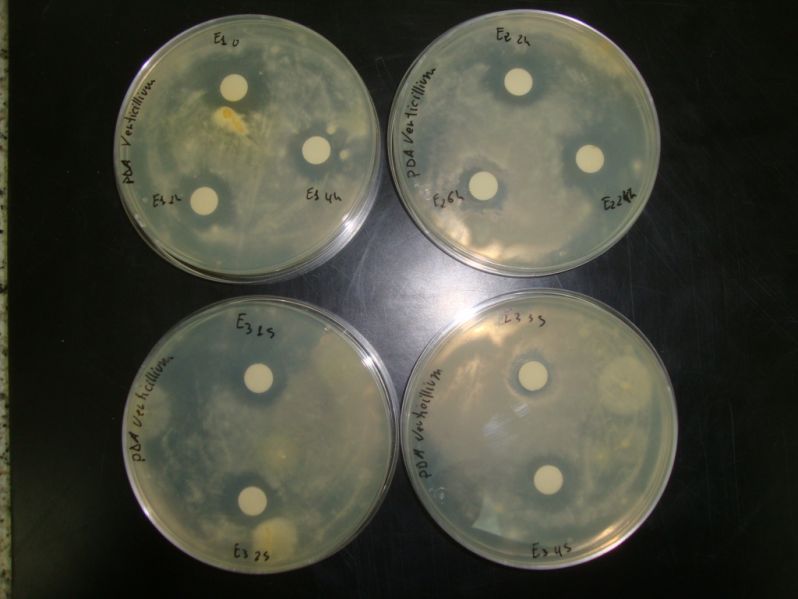
14 10 17 noticia caracterizacion pesticida

Avances del Proyecto
Estás aquí: Inicio Avances del Proyecto Ensayos caracterización del pesticida
Se han finalizado los ensayos de estabilidad del producto biocida elaborado a base de residuos de suero láctico y extracto de ajo (Acción B2 del proyecto), con el objetivo de evaluar la influencia de diversas condiciones medioambientales en la eficacia del producto.
Se han estudiados diversas variables como el pH y la dureza del agua utilizada para la preparación del producto a aplicar sobre los cultivos.
Igualmente se ha evaluado la estabilidad frente la exposición a luz ultravioleta, al oxígeno y a variaciones de temperatura.
Tras la realización de los ensayos se evaluó su capacidad biocida.
Ninguna de las variables mencionadas afecta a la efectividad del producto elaborado, como se demuestra en los halos de inhibición obtenidos.
« Investigadores portugueses de un proyecto de germoplasm...
» Segunda aplicación del biocida sobre el cultivo de oliv...
